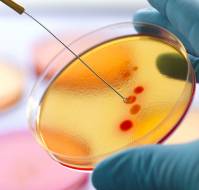

FAQs
FAQs
In this video, Dr. OP. Yadava, Chief Executive Officer & Chief Cardiac Surgeon, National Heart Institute, New Delhi, Talks about the results of Bypass Surgery in..
In this video, Dr. K K Aggarwal, Padma Shri Awardee, Editor-in-chief IJCP Publications, will talk on whether there is any formula to treat dengue fever. Dr. Aggarwal stat..
In This Video, Dr. K K Aggarwal, President Heart Care Foundation Of India And Group Editor In Chief MEDtalks, Talks About MDR TB As A Public Health Emergency. He Says Tha..
In this video, Dr. K K Aggarwal, President Heart Care Foundation of India and Group Editor in Chief MEDtalks, will discuss which is more serious LBB or RBB. He explains t..
In this video, Dr. K K Aggarwal, President Heart Care Foundation of India and Group Editor in Chief MEDtalks, will explain cha cha, pa pa, ka ka test, in this video. He e..
In this video, Dr. K K Aggarwal, Padma Shri Awardee, Editor-in-chief IJCP Publications, will talk whether non-medical persons can practice modern medicine after short-ter..
In this video, Dr. K K Aggarwal, Padma Shri Awardee, Editor-in-chief IJCP Publications, will discuss about what is an ideal bed occupancy rate? He states that the ideal b..
This video talks on whether doctors should undergo annual health check-ups by Dr. K K Aggarwal, Padma Shri Awardee, Editor-in-chief IJCP Publications. It is very importan..
In this video, Dr. Mahesh Verma, Padma Shri Awardee, President of Indian Academy of Restorative Dentistry (IARD) and Vice President of Dental Council of India. in this vi..
In this video, Dr. Kaberi Banerjee, Medical Director, Advanced Fertility & Gynecology Center, New Delhi, will discuss how to differentiate between the various kinds o..
In this video, Dr. Kaberi Banerjee, Medical Director, Advanced Fertility & Gynecology Center, New Delhi, will discuss whether single men or women surrogacy is allowed in ..
In this video, Dr. Kaberi Banerjee, Medical Director, Advanced Fertility & Gynecology Center, New Delhi talks about the evaluation for male infertility. Semen analysi..
The unethical acts in IVF are explained by Dr. Kaberi Banerjee, Medical Director, Advanced Fertility & Gynecology Center, New Delhi in this video. Unfortunately, unli..
Dr. Kaberi Banerjee, Medical Director, Advanced Fertility & Gynecology Center, New Delhi, will talk on laparoscopy in infertility in this video. Laparoscopy is an imp..
In this video, Dr. Kaberi Banerjee, Medical Director, Advanced Fertility & Gynecology Center, New Delhi, will explain about sonohysterogram in infertility. Sonohyster..
The video talks about the role of hysterosalpingogram in infertility by Dr. Kaberi Banerjee, Medical Director, Advanced Fertility & Gynecology Center, New Delhi. Hyst..
In this video, Dr. Kaberi Banerjee, Medical Director, Advanced Fertility & Gynecology Center, New Delhi, will discuss the role of hysteroscopy in infertility. Hystero..
The video talks about the role of testicular biopsy and male infertility by Dr. Kaberi Banerjee, Medical Director, Advanced Fertility & Gynecology Center, New Delhi. ..
Dr. Kaberi Banerjee, Medical Director, Advanced Fertility & Gynecology Center, New Delhi, will discuss the significance of varicocele and male infertility in this vid..
Dr. Kaberi Banerjee, Medical Director, Advanced Fertility & Gynecology Center, New Delhi, will discuss the treatment of endometriosis in this video. The treatment of ..
In this video, Dr. Nishi Gupta, Head department of ENT, Dr. Shroffs Charity Eye Hospital, Delhi, will discuss the most common problems of ear. The most common symptoms ar..
In this video, Dr. Nishi Gupta, Head department of ENT, Dr. Shroffs Charity Eye Hospital, Delhi, will discuss the serious problems which are related to discharge from the..
In this video, Dr. Nishi Gupta, Head department of ENT, Dr. Shroffs Charity Eye Hospital, Delhi, will discuss the treatment options in patients with long standing dischar..
In this video, Dr. Nishi Gupta, Head department of ENT, Dr. Shroffs Charity Eye Hospital, Delhi, talks about the cause of irreversible hearing loss in unsafe otitis media..
In this video, Dr. Nishi Gupta, Head department of ENT, Dr. Shroffs Charity Eye Hospital, Delhi, will bust the myth which is prevalent that ear surgery is not successful...
In this video, Dr. Nishi Gupta, Head department of ENT, Dr. Shroffs Charity Eye Hospital, Delhi, will talk about the complications if surgery in not done for unsafe chron..
In this video, Dr. Nishi Gupta, Head department of ENT, Dr. Shroffs Charity Eye Hospital, Delhi, will talk about the necessary steps to be taken if bleeding from the ear ..
In this video, Dr. Nishi Gupta, Head department of ENT, Dr. Shroffs Charity Eye Hospital, Delhi, Will discuss the treatment regimen for patients with hearing loss. Manage..
In this video, Dr. Nishi Gupta, Head department of ENT, Dr. Shroffs Charity Eye Hospital, Delhi, Will discuss the cases of unsafe CSOM whether hearing loss can be reverse..
In this video, Dr. Nishi Gupta, Head department of ENT, Dr. Shroffs Charity Eye Hospital, Delhi, Will tell about ossicular prostheses available in the market. There are a..
In this video, Dr. Nishi Gupta, Head department of ENT, Dr. Shroffs Charity Eye Hospital, Delhi, Will explain the screening tests for diagnosing patients presenting with ..
In this video, Dr. Nishi Gupta, Head department of ENT, Dr. Shroffs Charity Eye Hospital, Delhi, Will talk about the management if a child is born deaf. Dr. Nishi explain..
In this video, Dr. Nishi Gupta, Head department of ENT, Dr. Shroffs Charity Eye Hospital, Delhi, Will discuss the causes of giddiness related to ear problem. Ear problem ..
In this video, Dr. Manisha Agarwal, Vitreo-retina surgeon, Dr. Shroffs Charity Hospital, New Delhi, discusses about laser photo coagulation. One more method of managing t..
In this video, Dr. Manisha Agarwal, Vitreo-retina surgeon, Dr. Shroffs Charity Hospital, New Delhi, will discuss the treatment done for retinal detachment. A surgical tre..
In this video, Dr. Manisha Agarwal, Vitreo-retina surgeon, Dr. Shroffs Charity Hospital, New Delhi, explains about endophthalmitis in this video. Once the patient undergo..
In this video, Dr. Sunil Gupta, Additional Director, NCDC, will discuss the extent of antimicrobial resistance in India. The antimicrobial resistance is the serious probl..
In this video, Dr. Sunil Gupta, Additional Director, NCDC, will discuss whether antimicrobial resistance is a public health emergency or no. He will inform that as per th..
In this video, Dr. Sunil Gupta, Additional Director, NCDC, in this video, talks on the extent of resistance in falciparum malaria. He will inform that many countries and ..
In this video, Dr. Sunil Gupta, Additional Director, NCDC, will tell us whether there is any national policy regarding use of colistin. In animal sector, there are certai..
In this video, Dr. Sunil Gupta, Additional Director, NCDC, will talk about the common guidelines for antibiotic prescription in this video. The national guidelines were r..
In this video, Dr. Sunil Gupta, Additional Director, NCDC, in this video, will talk about the common gram-negative organisms showing antimicrobial resistance. He will tel..
In this video, Dr. Sunil Gupta, Additional Director, NCDC, explains the role of media in preventing antimicrobial resistance (AMR). He will discuss that media has a large..
In this video, Dr. Ramneek Mahajan, Director - Orthopedics & Joint Replacement, Max Smart Super Specialty Hospital, New Delhi, talks about osteoarthritis in pregnancy. He..
In this video, Dr. Ramneek Mahajan, Director - Orthopedics & Joint Replacement, Max Smart Super Specialty Hospital, New Delhi, will talk on the role of glucosamine in ost..
In this video, Dr. Pawanindra Lal, Director, Professor of Surgery, Maulana Azad Medical College, will talk about the prerequisites of setting up a skill lab. A space is n..
In this video, Dr. RR Kasliwal, Chairman - Clinical & Preventive Cardiology, Medanta – The Medicity, will discuss how about endothelial functions. Endothelium is the firs..
In this video, Dr. RR Kasliwal, Chairman - Clinical & Preventive Cardiology, Medanta – The Medicity, will discuss about penile vascular disease. In penile vascular diseas..
In this video, Dr. R. R Kasliwal, Chairman - Clinical & Preventive Cardiology, Medanta – The Medicity, will discuss the importance of LVH on echocardiography. When LVH is..
In this video, Dr. R. R Kasliwal, Chairman - Clinical & Preventive Cardiology, Medanta – The Medicity, will talk on renal artery atherosclerosis and how to investigate it..
In this video, Dr. Narendra Saini, MBBS, MD, Internal / General Medicine, will talk on liabilities tool for occult blood. Occult blood means the blood is passing through ..
The video talks about the treatment of aortic stenosis in children by Dr. Smita Mishra, Paediatric Cardiologist, Associate Director - Jaypee Hospital. The aortic stenosis..
In this video, Dr. Smita Mishra, Paediatric Cardiologist, Associate Director - Jaypee Hospital, will explain about balloon arterial septostomy. The balloon arterial septo..
In this video, Dr. Smita Mishra, Paediatric Cardiologist, Associate Director - Jaypee Hospital, will explain tetralogy of Fallot. It means that there is a large hole in t..
Dr. Smita Mishra, Paediatric Cardiologist, Associate Director - Jaypee Hospital, will explain atrial septal defect (ASD) in this video. In this defect, the baby usually r..
In this video, Dr. K K Aggarwal, Padma Shri Awardee, Editor-in-chief, IJCP Publications, will talk about violence on doctors in Bangladesh. There are lot of incidences of..
Dr. K K Aggarwal, Padma Shri Awardee, Editor-in-chief, IJCP Publications, will discuss on the topic of violence on doctors in Pakistan in this video. In Pakistan, there a..
This video talks about the views on post suicidal attempt treatment presented by Dr. Brahmdeep Sindhu, Psychiatrist, Stress Management and Drug Addiction. In a suicidal a..
In this video, Dr. Brahmdeep Sindhu, Psychiatrist, Stress Management and Drug Addiction, will talk on the new treatment modalities in OCD. Repetitive Transcranial Magneti..
Dr. J S Pasricha, Retired Professor, Department of Dermatology and Venereology, AIIMS, New Delhi will talk about the treatment of psoriasis in this video. Psoriasis is an..
The video will talk about the treatment of vitiligo by Dr. J S Pasricha, Retired Professor, Department of Dermatology and Venereology, AIIMS, New Delhi. He will explain t..
In this video, Dr. J S Pasricha, Retired Professor, Department of Dermatology and Venereology, AIIMS, New Delhi will explain systemic sclerosis. It is a group of diseases..
In this video, Dr. Deepak N Amarapurkar, Gastroenterologist, Bombay Hospital & Medical Research Center, will discuss the management of peptic ulcer disease. The main goal..
Dr. Rajesh Chawla, Senior Consultant, Institutes of Critical Care Respiratory and Sleep Medicine, Indraprastha Apollo Hospitals, New Delhi, will discuss how to diagnose p..
In this video, Dr. Suman Kirti, Endocrinologist, Holy Family Hospital, New Delhi will talk about what can a patient take during the fasting period? During the fasting per..
In this video, Dr. Suman Kirti, Endocrinologist, Holy Family Hospital, New Delhi talks about whether glycemic control can minimize the risk of diabetic nephropathy. Dr. S..
In this video, Dr. Suman Kirti, Endocrinologist, Holy Family Hospital, New Delhi will talk about the aggressive management of hypertension in all cases of diabetes and wh..
In this video, Dr. Suman Kirti, Endocrinologist, Holy Family Hospital, New Delhi will talk about a patient who has nephropathy and what should be done in this case Glycem..
In this video, Dr. Suman Kirti, Endocrinologist, Holy Family Hospital, New Delhi will talk about diagnosing nephropathy in a diabetic patient. Generally, a type 2 diabeti..
In this video, Dr. Suman Kirti, Endocrinologist, Holy Family Hospital, New Delhi talks about when and at what stage diabetes can be reversed? Prediabetes if diagnosed at ..
In this video, Dr. Suman Kirti, Endocrinologist, Holy Family Hospital, New Delhi will give insights about the alternative treatment to be given if the patient cannot tole..
In this video, Dr. Suman Kirti, Endocrinologist, Holy Family Hospital, New Delhi, talks whether all diabetic patients should receive ACE inhibitors. If the following cond..
Glycated hemoglobin (HbA1c) is a form of hemoglobin which is measured primarily to identify the three-month average plasma glucose concentration. In this video, Dr. Suman..
In this video, Dr. Suman Kirti, Endocrinologist, Holy Family Hospital, New Delhi, talks about the equation between A1C and blood sugar. Blood sugar is equal to HbA1c mult..
In this video, Dr. Muruganathan, MD, FRCP, FACP, FPCP, FICP, Internist, Tirupur, will talk about the biggest disease burden in India. In India, the biggest burden is non-..
Dr. Suman Kirti, Endocrinologist, Holy Family Hospital, New Delhi, talks about the goals of glycated hemoglobin or HbA1c in diabetic patients. American Diabetes Associati..
In this video, Dr. Suman Kirti, Endocrinologist, Holy Family Hospital, New Delhi, will explain about metabolic memory. Metabolic memory is a term used to describe benefic..
In this video, Dr. Arvind Gupta, Director and Consultant Physician at Jaipur Diabetes Research Center in Jaipur, Rajasthan, will discuss the principles of diet in diabete..
Dr. Sarita Bajaj, Endocrinologist, Director and Head of Medicine, Motilal Nehru College, Allahabad will discuss whether glucometer readings give confirmation of diabetes ..
Dr. Sanjay Kalra, Endocrinologist, Karnal, Haryana, will talk on the topic of living with diabetes in this video. Many people cannot cope with the challenge living with d..
Dr. Sanjay Agarwal, MD, Internal Medicine, Consultant Diabetes and Medicine, Pune will talk on the topic of living with diabetes in this video. Diabetes does not show sym..
The video talks about diabetes in women and pregnancy by Dr. Sunil Gupta, Diabetologist, Nagpur. Diabetes in pregnancy is a big challenge but it is possible that a young ..
Dr. Shilpa Joshi, Consultant Dietician, Mumbai, will talk about lifestyle intervention tips to prevent and manage diabetes in this video. She discusses that with right ki..
Dr. Anuj Maheshwari, MBBS, MD-General Medicine, Lucknow will talk on the topic about reducing burden of diabetes in this video. Food habits are changing in Indian people ..
Dr. Anuj Maheshwari, MBBS, MD-General Medicine, Lucknow will talk about Diacon 2018 in this video. He says that it is a conference attended for by more than 1000 delegate..
Dr. Sudhir Bhandari, Cardiologist, Jaipur will talk about DIACON 2018, which was at Ahmedabad. He will talk on the concept of newer antidiabetic management in this meetin..
Dr. David Strain, Senior Clinical Lecturer, England, will talk about the importance of talking to your doctor about diabetes in this video. When the diabetes is diagnosed..
Dr. Rakesh Sahay, HOD of Endocrinology, Hyderabad, will discuss about many diabetic patients refuse to take insulin in this video. Many patients feel that if they take in..
Dr. R K Marya, Diabetologist, Delhi will discuss about the lifestyle intervention in diabetes in this video. Diabetes has become an epidemic in India. Even children sit a..
In this video, Dr. J Jayaprakashsai, Diabetologist, Hyderabad, will discuss the best approach for diabetes patients. Awareness and education is very important in preventi..
Dr. Rajeev Chawla, Director of Diabetes Center, New Delhi, will discuss about the tips used while diagnosing diabetes in this video. He talks about disciplining the diet,..
In this video, Dr. Chitra Selvan, Endocrinologist, Bangalore will discuss about the connection between women & diabetes. Women with diabetes needs aggressive treatment as..
Dr. Indira Maisnam, Endocrinologist, Kolkata, will talk about diabetes & obesity in the Indian context in this video. India has got the second highest number of diabetes ..
In this video, Dr Ashish Dengra Diabetologist based in Jabalpur. Answers "3 things that should always be remembered if you have diabetes"..
Dr. Manisha Sahai, HOD of Nephrology, Osmania General Hospital, Hyderabad will talk on kidney diseases in diabetes patients in this video. Kidney diseases have become ver..
In this video, Dr. Sunil Dargar, MBBS, MD, Pathologist, New Delhi, will talk how reliable is stool occult blood In a stool sample, the occult blood is the second most fre..
In this video, Dr. Sunil Dargar, MBBS, MD, Pathologist, New Delhi, will talk about the urine tests and how it is collected. Urine test is one of the most frequently presc..
In this video, Dr. Sunil Dargar, MBBS, MD, Pathologist, New Delhi, talks about the significance of pleural fluid ADA test. Pleural tapping has been sent for ADA test and ..
In this video, Dr. Sunil Dargar, MBBS, MD, Pathologist, New Delhi, discusses the relationship between BUN and urea. Urea is a protein waste metabolite with nitrogenous mo..
In this video, Dr. Jayanta Panda, Professor of Medicine at SCB Medical College, Cuttack, will talk about other forms of diabetes in the young. One form is malnutrition mo..
In this video, Dr. Jayanta Panda, Professor of Medicine at SCB Medical College, Cuttack, will talk about the age when diabetes start. He states that type 1 diabetes start..
In this video, Dr. Atul Verma, Head Dept. of Nuclear Medicine, Fortis Hospital, New Delhi, will talk about the other fields for nuclear medicine. Dr. Atul tells us that i..
In this video, Dr. Atul Verma, Head Dept. of Nuclear Medicine, Fortis Hospital, New Delhi, discusses various points to be addressed in myocardial perfusion scintigraphy. ..
In this video, Dr. Minal Mohit, Diabetes & Endocrinology, Manipal Hospital, Jaipur answer "Menopause in women with diabetes"..
In this video, Dr. Minal Mohit, Diabetes & Endocrinology, Manipal Hospital, Jaipur answer "Is Diabetes in women different from diabetes in men"..
In this video, Dr. Minal Mohit, Diabetes & Endocrinology, Manipal Hospital, Jaipur answer "why do women behave differently with diabetes"..
In this video, Dr. Minal Mohit, Diabetes & Endocrinology, Manipal Hospital, Jaipur, will talk about complications of diabetes in women. The complications of diabetes are ..
Dr. K K Kalra, Former CEO, NABH, will talk about the need for quality and patient safety in this video. The concept of quality and patient safety is very old. Dr. Kalra w..
Dr. K K Kalra, Former CEO, NABH, will discuss about the responsibility to ensure quality in health care in this video. The whole medical team is responsible for ensuring ..
In this video, Dr. P K Julka, Senior Director, Oncology Daycare Centre, Lajpat Nagar, New Delhi, will talk about the inflammatory breast cancers. Certain breast cancers a..
Dr. P K Julka, Senior Director, Oncology Daycare Centre, Lajpat Nagar, New Delhi, will talk on prophylactic breast removal in this video. He says that for prophylactic re..
Dr. Viveka Kumar, Senior Director - Cath Lab, Max Super Speciality Hospital, Saket, will talk about the role of ticagrelor in acute MI, in this video. Ticagrelor has revo..
In this video, Dr. Sathyanarayana Rao, Professor of Psychiatry, JSS Medical College, Mysore Answer "Please give your views on post suicidal attempt treatment"..
This video talks about the screening of PSA by Dr. P K Julka, Senior Director, Oncology Daycare Center, Lajpat Nagar, New Delhi. PSA should be done in elderly age group a..
In this video, Dr. P K Julka, Senior Director, Oncology Daycare Center, Lajpat Nagar, New Delhi, will explain about the 5 years survival rate. Five year survival rate is ..
Dr. Anil Gurnani, Group Director, Intensive Care & Anesthesiology, Kailash Group of Hospitals, will talk on the vasopressor blood targets in critically ill patients with ..
Dr. Anil Gurnani, Group Director, Intensive Care & Anesthesiology, Kailash Group of Hospitals, will discuss the management of patients with diabetic ketoacidosis, in this..
In this video, Dr. Anil Gurnani, Group Director, Intensive Care & Anesthesiology, Kailash Group of Hospitals, will talk on the management of status epilepticus. He will t..
In this video, Dr. N S Sengar, Nephrologist, Jhansi, Uttar Pradesh, will talk about hypertensive and diabetic medications. The swelling could be due to drug induced and r..
In this video, Dr. Chittaranjan Kar, Professor of Nephrology, Cuttack, will talk whether anyone could get kidney disease. Not all people are predisposed to kidney disease..
In this video, Dr. Umapati Narasinha Hegde, Consultant Nephrologist, Gujarat will discuss about antihypertensive and PPI therapy. Recent evidences have shown that in long..
In this video, Dr. Ved Chaturvedi, Rheumatologist, Sir Ganga Ram Hospital, Delhi, will talk about diagnostic evaluation for rheumatoid arthritis. A new test has come know..
The video talks about the management of rheumatoid arthritis by Dr. Ved Chaturvedi, Rheumatologist, Sir Ganga Ram Hospital, Delhi. He says that the confirmation of rheuma..
In this video, Dr Vinod Mittal, Sr. Diabetologist & Physician Specialist in Life Style Diseases, answers "Can insulin be safely used in diabetic kidney disease"..
In this video, Dr. Vinod Mittal, Senior Diabetologist, Delhi Heart and Lung Institute, will discuss about the medications which are safe in diabetic kidney disease. Metfo..
Dr. Vinod Mittal, Senior Diabetologist, Delhi Heart and Lung Institute, will talk about metformin used in diabetic kidney disease in this video. Metformin is the first li..
Dr. Vinod Mittal, Senior Diabetologist, Delhi Heart and Lung Institute, will talk about the medications which are safe in diabetes kidney disease in this video. In diabet..
In this video, Dr. Vinod Mittal, Senior Diabetologist, Delhi Heart and Lung Institute, will discuss the important parameter to diagnose kidney disease in type 2 diabetes ..
In this video, Dr. Vinod Kumar Singh, Senior Consultant, Critical Care, Sri Ganga Ram Hospital, New Delhi will discuss the management of status asthmaticus. It is a life-..
In this video, Dr. Ragini Agrawal, Obstetrician, Gynecologist, Laparoscopic Surgeon and Aesthetic Gynecologist, W Pratiksha Hospital, Gurgaon, will talk about the cord bl..
Dr. Parag Singhal, Endocrinologist, UK will talk about the role of doctors in addressing global health challenges in this video. Expense of health care facilities are inc..
In this video, Dr. Parag Singhal, Endocrinologist, UK will discuss about the tests required for enlargement of thyroid gland. Enlargement of thyroid is very common in end..
Dr. Parag Singhal, Endocrinologist, UK will discuss about the response while treating new diabetic patients with new antidiabetic medications in this video. Type 2 diabet..
Dr. J P Tiwari, Prof and Head of Nephrology, Goa Medical College, Goa will discuss about hypertension and diabetes in this video. There are high chances to develop diabet..
Dr. N P Singh, Senior Director, Max Super Specialty Hospital, Delhi, will talk on the probable questions on renal failure in this video. The most probable question can be..
In this video, Dr. Jaya Pancholy, Integrative Holistic Medicine Practitioner, USA, will discuss the integration of holistic modalities into medical profession. She says t..
Dr. Jaya Pancholy, Integrative Holistic Medicine Practitioner, USA, will talk about role of Ayush in contraception in this video. Ayurveda is an ancient old medicine prac..
In this video, Dr. Philip A Masters, Vice President of Membership and International Programs at the American College of Physicians (ACP), answer "Advice for Indian Citize..
In this video, Dr. Philip A Masters, Vice President of Membership and International Programs at the American College of Physicians (ACP), answer "What is ACP India Chapte..
In this video, Dr. Varsha Prapanna, Gynecologists and Obstetricians in Vadodara, Gujarat, answer "Does GP have any role in reducing Maternal mortality"..
In this video, Dr. Ramesh Hotchandani, Nephrologist, answers "Why urine examination is called liquid kidney disease biopsy"..
In this video, Dr. Ramesh Hotchandani, Nephrologist, answers "How should we manage patients of mild kidney disease in patients with GFR more than 60"..
In this video, Dr. Ramesh Hotchandani, Nephrologist, answers "What is the role of erythropoietin in patients with CKD"..
In This Video, Dr. Bhavatharini Aruyerchelvan, Diabetologist, Erode, Tamilnadu, India, Answer "How should we Prevent Diabetes"..
In This Video, Dr. V Seshiah, Past Head of the Department of Diabetology, Madras Medical College and Government General Hospital, Answer "How should we Prevent Diabetes"..
The video talks about mild acidity and its management by Dr. K K Aggarwal, President Heart Care Foundation of India and Group Editor in Chief MEDtalks. In gastro-enteral ..
In this video, Dr. K K Aggarwal, President Heart Care Foundation of India and Group Editor in Chief MEDtalks, will talk whether hepatitis C is curable or not. He confirms..
The video will discuss about whether a person with acute appendicitis can have normal appendix during surgery by Dr. K K Aggarwal, President Heart Care Foundation of Indi..
Dr. K K Aggarwal, President Heart Care Foundation of India and Group Editor in Chief MEDtalks, will talk about acute uncomplicated cystitis in this video. Dr. Aggarwal sa..
In this video, Dr. K K Aggarwal, President Heart Care Foundation of India and Group Editor in Chief MEDtalks, will talk about the situations of carbon monoxide poisoning ..
Dr. K K Aggarwal, President Heart Care Foundation of India and Group Editor in Chief MEDtalks, will explain in details about obstructive sleep apnea in this video. It mea..
Dr. K K Aggarwal, President Heart Care Foundation of India and Group Editor in Chief MEDtalks, will talk about the gall bladder surgery in a patient with acute cholecysti..
The video talks whether Zika cases has been seen or observed in India by Dr. K K Aggarwal, President Heart Care Foundation of India and Group Editor in Chief MEDtalks. He..
In this video, Dr. K K Aggarwal, President Heart Care Foundation of India and Group Editor in Chief MEDtalks, will discuss about any association between smoking and infla..
Dr. K K Aggarwal, President Heart Care Foundation of India and Group Editor in Chief MEDtalks, will talk regarding better sleep and is there a need for a zero watt red bu..
In this video, Dr. K K Aggarwal, President Heart Care Foundation of India and Group Editor in Chief MEDtalks, will discuss about the classification and treatment of clost..
Dr. K K Aggarwal, President Heart Care Foundation of India and Group Editor in Chief MEDtalks, will talk on the topic whether smelly urine is a sign of diabetes in this v..
The video will discuss the tests done for diagnosing acute appendicitis by Dr. K K Aggarwal, President Heart Care Foundation of India and Group Editor in Chief MEDtalks. ..
Dr. K K Aggarwal, President Heart Care Foundation of India and Group Editor in Chief MEDtalks, will discuss the management of asymptomatic gallstones in the diabetic pati..
Dr. K K Aggarwal, President Heart Care Foundation of India and Group Editor in Chief MEDtalks, will discuss the differential diagnosis in biliary colic patient in this vi..
In this video, by Dr. K K Aggarwal, President Heart Care Foundation of India and Group Editor in Chief MEDtalks, will discuss about the asymptomatic gallstones. Asymptoma..
In this video, Dr. K K Aggarwal, President Heart Care Foundation of India and Group Editor in Chief MEDtalks, will discuss the beneficial effect of nuts in diabetes patie..
The video will discuss whether it is difficult to treat dementia in diabetes by Dr. K K Aggarwal, President Heart Care Foundation of India and Group Editor in Chief MEDta..
Dr. K K Aggarwal, President Heart Care Foundation of India and Group Editor in Chief MEDtalks, will discuss whether it is necessary to give a rabies prophylaxis after a r..
The video will discuss whether a single episode of loose motion can be termed as traveller’s diarrhea in foreigner traveler by Dr. K K Aggarwal, President Heart Care Foun..
In this video, Dr. K K Aggarwal, President Heart Care Foundation of India and Group Editor in Chief MEDtalks, will talk about any guideline recommended for normal SGOT an..
In this video, Dr. K K Aggarwal, President Heart Care Foundation of India and Group Editor in Chief MEDtalks, will talk on abdominal obesity. The abdominal circumference ..
Dr. K K Aggarwal, President Heart Care Foundation of India and Group Editor in Chief MEDtalks, will explain PSA velocity in this video. It is the change in the PSA level ..
In this video, Dr. K K Aggarwal, President Heart Care Foundation of India and Group Editor in Chief MEDtalks, will talk about the residual urine during ultrasound of a pr..
The video will discuss about the takayasu disease by Dr. K K Aggarwal, President Heart Care Foundation of India and Group Editor in Chief MEDtalks. It is a rare autoimmun..
The video will discuss about persistent tachycardia by Dr. K K Aggarwal, President Heart Care Foundation of India and Group Editor in Chief MEDtalks. Persistent tachycard..
The video will talk about the follow up of a patient with mitral stenosis by Dr. K K Aggarwal, President Heart Care Foundation of India and Group Editor in Chief MEDtalks..
The video will discuss about a patient with normal CRP having high ESR by Dr. K K Aggarwal, President Heart Care Foundation of India and Group Editor in Chief MEDtalks. H..
In this video, Dr. K K Aggarwal, President Heart Care Foundation of India and Group Editor in Chief MEDtalks, will discuss the prognostic tests to diagnose sepsis. CRP an..
In this video, Dr. K K Aggarwal, President Heart Care Foundation of India and Group Editor in Chief MEDtalks, will discuss about the role of levamisole in steroid depende..
In this video, Dr. K K Aggarwal, President Heart Care Foundation of India and Group Editor in Chief MEDtalks, will discuss the association between work stress in heart di..
In this video, Dr. K K Aggarwal, President Heart Care Foundation of India and Group Editor in Chief MEDtalks, will discuss the penicillin prophylaxis for treatment of rhe..
Dr. K K Aggarwal, President Heart Care Foundation of India and Group Editor in Chief MEDtalks, will discuss whether marijuana can be used as a drug in epilepsy in this vi..
Dr. K K Aggarwal, President Heart Care Foundation of India and Group Editor in Chief MEDtalks will discuss whether dabigatran can be prescribed in patients with atrial fi..
In this video, Dr. K K Aggarwal, President Heart Care Foundation of India and Group Editor in Chief MEDtalks, answer "What is the most common cause of aortic regurgitatio..
In this video, Dr. K K Aggarwal, President Heart Care Foundation of India and Group Editor in Chief MEDtalks, answer "Characteristics of angina"..
The video talks about dyspepsia and gas and the reason behind it by Dr. K K Aggarwal, President Heart Care Foundation of India and Group Editor in Chief MEDtalks. He will..
Dr. K K Aggarwal, President Heart Care Foundation of India and Group Editor in Chief MEDtalks, will discuss about irritable bowel syndrome related to stress in this video..
Dr. Shiv Chopra, General Surgery Senior Consultant, Mool Chand Hospital, New Delhi, will explain the anorectal conditions in this video. Piles are usually painless, painf..
In this video, Dr. Shiv Chopra, General Surgery Senior Consultant, Mool Chand Hospital, New Delhi, answer, "Is it okay to pop a blister that formed after a burn"..
In this video, Dr. Shiv Chopra, General Surgery Senior Consultant, Mool Chand Hospital, New Delhi, answer, "When should a burn send you to the hospital"..
In this video, Dr. Shiv Chopra, General Surgery Senior Consultant, Mool Chand Hospital, New Delhi, answer, "What might have caused an infection at the site of surgery"..
In this video, Dr. Shiv Chopra, General Surgery Senior Consultant, Mool Chand Hospital, New Delhi, answer, "Wrong site surgery and surgical marking practices among clinic..
In this video, Dr. Shiv Chopra, General Surgery Senior Consultant, Mool Chand Hospital, New Delhi, answer, "Use of mobile phone in operating room"..
In this video, Dr. Shiv Chopra, General Surgery Senior Consultant, Mool Chand Hospital, New Delhi, answer, "Comparison between fine needle aspiration cytology (FNAC) and ..
In this video, Dr. Shiv Chopra, General Surgery Senior Consultant, Mool Chand Hospital, New Delhi, answer, "Can a biopsy cause a cancer to spread"..
In this video, Dr. K K Aggarwal, President Heart Care Foundation of India and Group Editor in Chief MEDtalks, answer "Who was Raja Dasrath in Dr K K Aggarwals adwait Rama..
In this video, Dr. K K Aggarwal, President Heart Care Foundation of India and Group Editor in Chief MEDtalks, answer "What is spirituality? How can one awaken spiritual p..
In this video, Dr. K K Aggarwal, President Heart Care Foundation of India and Group Editor in Chief MEDtalks, answer "Movement Disorder: Understanding the Ayurvedic Appro..
In this video, Dr. K K Aggarwal, President Heart Care Foundation of India and Group Editor in Chief MEDtalks, answer "The Different Aspects of Vayu, Vata and Prana"..
In this video, Dr. K K Aggarwal, President Heart Care Foundation of India and Group Editor in Chief MEDtalks, answer "The Four Varieties of Agni"..
In this video, Dr. K K Aggarwal, President Heart Care Foundation of India and Group Editor in Chief MEDtalks, answer "Common Cold - The Ayurvedic Way of Treating It"..
In this video, Dr. K K Aggarwal, President Heart Care Foundation of India and Group Editor in Chief MEDtalks, answer "The Seven Dhatus (tissues) in Ayurvedic Medicine"..
In this video, Dr. K K Aggarwal, President Heart Care Foundation of India and Group Editor in Chief MEDtalks, answer "Four Mahavakyas: Essence of the Upanishads"..
In this video, Dr. Neena Malhotra, Obstetrician and Gynaecologist, Delhi, will talk about the new updates in 2017. She talks about the plan which is launched by our Prime..
Dr. Neena Malhotra, Obstetrician and Gynaecologist, Delhi, will talk about the difference between metabolic syndrome and PCOS in this video. She says that it can be terme..
The video talks about the differentiating points about glomerular and tubulointerstitial CKD by Dr. Sanjay Kumar Agarwal, Professor and Head of Nephrology, AIIMS. Glomeru..
Dr. Sanjay Kumar Agarwal, Professor and Head of Nephrology, AIIMS, will talk about chronic kidney disease and NSAIDs in this video. NSAIDs can worsen the chronic kidney d..
In this video, Dr. Sanjay Kumar Agarwal, Professor and Head of Nephrology, AIIMS, will discuss about certain drugs and its effect on CKD patients. Paracetamol is safe in ..
The video talks about data regarding omeprazole in CKD patients by Dr. Sanjay Kumar Agarwal, Professor and Head of Nephrology, AIIMS. He says that this topic is controver..
In this video, Dr. Sanjay Kumar Agarwal, Professor and Head of Nephrology, AIIMS, will discuss if any relation between omeprazole and progression of CKD in a normal perso..
Dr. Sanjay Kumar Agarwal, Professor and Head of Nephrology, AIIMS, will explain the calcium phosphorus metabolism in this video. In CKD patient, there is an increase in p..
In this video, Dr. Sanjay Kumar Agarwal, Professor and Head of Nephrology, AIIMS, will discuss about calcium carbonate versus calcium acetate. Both have similar physiolog..
Dr. Sanjay Kumar Agarwal, Professor and Head of Nephrology, AIIMS, will talk about the different investigations while evaluating CKD in this video. He says that the decis..
Dr. Sanjay Kumar Agarwal, Professor and Head of Nephrology, AIIMS, will discuss whether the renal cell carcinoma is on rise in this video. He says that renal cell carcino..
In this video, Dr. Sanjay Kumar Agarwal, Professor and Head of Nephrology, AIIMS, will discuss about the diabetic patient, hypoglycemia and association with CKD. He says ..
Dr. Sanjay Kumar Agarwal, Professor and Head of Nephrology, AIIMS, will talk about initiating statins in a patient with CKD in this video. He says that if the CKD patient..
Dr. K K Aggarwal, President Heart Care Foundation of India and Group Editor in Chief MEDtalks, will discuss whether same type of disease spread in every Indian in this vi..
Dr. K K Aggarwal, President Heart Care Foundation of India and Group Editor in Chief MEDtalks, will talk whether Viagra is given in pregnancy in this video. Viagra should..
The video will discuss about the precautions to be taken while dealing with the patient of acute heart attack by Dr. K K Aggarwal, President Heart Care Foundation of Indi..
In this video, Dr. K K Aggarwal, President Heart Care Foundation of India and Group Editor in Chief MEDtalks, will talk about the difference between an embolic stroke and..
Dr. K K Aggarwal, President Heart Care Foundation of India and Group Editor in Chief MEDtalks, will discuss about constrictive pericarditis and its clinical presentation ..
In this video, Dr. Ishi Khosla, Clinical Nutritionist, Delhi, will discuss whether wheat is a problem to Indian people. Wheat has a protein called gluten which is not com..
In this video, Dr. Ishi Khosla, Clinical Nutritionist, Delhi, will discuss about dairy products. There are lot of adulterations in milk products and the quality of milk. ..
In this video, Dr. Arvind Garg, Consultant Pediatrician, Apollo Hospital, Noida, will discuss the causes of stomach pain in children. Children who suffer from stomach pai..
In this video, Dr. K K Aggarwal, President Heart Care Foundation of India and Group Editor in Chief MEDtalks, answer "Is it important to diabetes keep in control"..
In this video, Dr. K K Aggarwal, President Heart Care Foundation of India and Group Editor in Chief MEDtalks, answer "What is Myasthenia gravis"..
Filter Speciality


 Dr. OP Yadava
Dr. OP Yadava 
 Dr. KK Aggarwal
Dr. KK Aggarwal 






 Dr. Mahesh Verma
Dr. Mahesh Verma 
 Dr. Kaberi Banerjee
Dr. Kaberi Banerjee 










 Dr. Nishi Gupta
Dr. Nishi Gupta 












 Dr. Manisha Agarwal
Dr. Manisha Agarwal 


 Dr. Sunil Gupta
Dr. Sunil Gupta 






 Dr. Ramneek Mahajan
Dr. Ramneek Mahajan 


 Dr. RR Kasliwal
Dr. RR Kasliwal 



 Dr. Narendra Saini
Dr. Narendra Saini 
 Dr. Smita Mishra
Dr. Smita Mishra 





 Dr. Brahmdeep Sindhu
Dr. Brahmdeep Sindhu 

 Dr. J S Pasricha
Dr. J S Pasricha 


 Dr. Deepak Narayan Amarapurkar
Dr. Deepak Narayan Amarapurkar 
 Dr. Rajesh Chawla
Dr. Rajesh Chawla 
 Dr. Suman Kirti
Dr. Suman Kirti 









 Dr. A Muruganathan
Dr. A Muruganathan 


 Dr. Arvind Gupta
Dr. Arvind Gupta 
 Dr. Sarita Bajaj
Dr. Sarita Bajaj 
 Dr. Sanjay Kalra
Dr. Sanjay Kalra 
 Dr. Sanjay Agarwal
Dr. Sanjay Agarwal 
 Dr. Sunil Gupta
Dr. Sunil Gupta 
 Dr. Shilpa Joshi
Dr. Shilpa Joshi 
 Dr. Anuj Maheshwari
Dr. Anuj Maheshwari 

 Dr. Sudhir Bhandari
Dr. Sudhir Bhandari 
 Dr. David Strain
Dr. David Strain 
 Dr. Rakesh Kumar Sahay
Dr. Rakesh Kumar Sahay 
 Dr. R.K Marya
Dr. R.K Marya 
 Dr. Jayaprakash Sai
Dr. Jayaprakash Sai 
 Dr. Rajeev Chawla
Dr. Rajeev Chawla 
 Dr. Chitra Selvan
Dr. Chitra Selvan 
 Dr. Indira Maisnam
Dr. Indira Maisnam 
 Dr. Ashish Dengra
Dr. Ashish Dengra 
 Dr. Manisha Sahay
Dr. Manisha Sahay 
 Dr. Sunil Dargar
Dr. Sunil Dargar 



 Dr. Jayanta Panda
Dr. Jayanta Panda 

 Dr. Atul Verma
Dr. Atul Verma 
.jpg.jpg)
 Dr. Minal Mohit
Dr. Minal Mohit 



 Dr. KK Kalra
Dr. KK Kalra 

 Dr. Pramod Kumar Julka
Dr. Pramod Kumar Julka 


 Dr. TS Sathyanarayana Rao
Dr. TS Sathyanarayana Rao 


 Dr. Anil Gurnani
Dr. Anil Gurnani 


 Dr. Narender Sengar
Dr. Narender Sengar 
 Dr. Chitaranjan kar
Dr. Chitaranjan kar 
 Dr. Umapati Narasinha Hegde
Dr. Umapati Narasinha Hegde 
 Dr. Ved Chaturvedi
Dr. Ved Chaturvedi 

 Dr. Vinod Mittal
Dr. Vinod Mittal 




 Dr. Vinod Kumar Singh
Dr. Vinod Kumar Singh 
 Dr. Ragini Agarwal
Dr. Ragini Agarwal 
 Dr. Parag Singhal
Dr. Parag Singhal 


 Dr. JP Tiwari
Dr. JP Tiwari 
 Dr. N P Singh
Dr. N P Singh 
 Dr. Jaya Pancholy
Dr. Jaya Pancholy 

 Dr. Phillip A Masters
Dr. Phillip A Masters 

 Dr. Varsha Prapanna
Dr. Varsha Prapanna 
 Dr. Ramesh Hotchandani
Dr. Ramesh Hotchandani 


 Dr. N Bhavatharini
Dr. N Bhavatharini 
 Dr. V Seshiah
Dr. V Seshiah

Dr. Shiv Chopra
Dr. Shiv Chopra 















 Dr. Neena Malhotra
Dr. Neena Malhotra 

 Dr. Sanjay Kumar Agarwal
Dr. Sanjay Kumar Agarwal 















 Dr. Ishi Khosla
Dr. Ishi Khosla 

 Dr. Arvind Garg
Dr. Arvind Garg 

